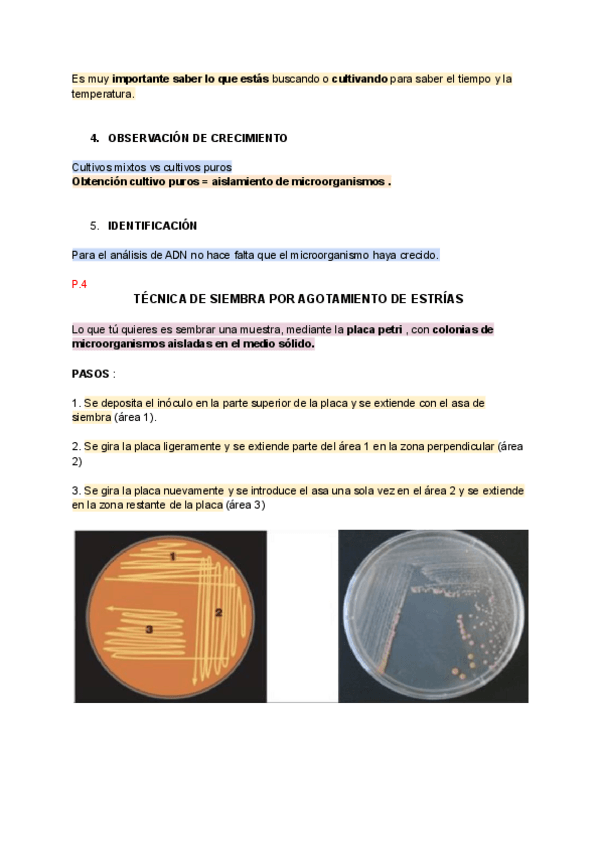

Microbiología y Parasitología
He publicado nuevos apuntes de 1º Microbiología y Parasitología: T19.-Parasitos.-Helmitos.pdf
He publicado nuevos apuntes de 1º Microbiología y Parasitología: T1.-Introduccion.pdf
He publicado nuevos apuntes de 1º Microbiología y Parasitología: T3.-Taxonomia.pdf
He publicado nuevos apuntes de 1º Microbiología y Parasitología: T5.-Procariota.pdf
He publicado nuevos apuntes de 1º Microbiología y Parasitología: T7.-Crecimiento-bacteriano.pdf
He publicado nuevos apuntes de 1º Microbiología y Parasitología: T11.-Mecanismos-de-infectividad-bacteriana.pdf
He publicado nuevos apuntes de 1º Microbiología y Parasitología: T16.-Bacterias-Grampositivas-transmitidas-por-alimentos.pdf
He publicado nuevos apuntes de 1º Microbiología y Parasitología: T13.-Virus-en-alimentos.pdf
He publicado nuevos apuntes de 1º Microbiología y Parasitología: T8.-genetica-bacteriana.pdf
He publicado nuevos apuntes de 1º Microbiología y Parasitología: T9.-Esterilizacion-y-desinfeccion.pdf
He publicado nuevos apuntes de 1º Microbiología y Parasitología: T18.-Parasitos.-Protozoos.pdf
He publicado nuevos apuntes de 1º Microbiología y Parasitología: T10.-Antimicrobianos.pdf
He publicado nuevos apuntes de 1º Microbiología y Parasitología: T4.-Metodos-de-estudio-de-los-microorganismos..pdf
He publicado nuevos apuntes de 1º Microbiología y Parasitología: T6.-NUTRICION-Y-METABOLISMO-BACTERIANO.pdf
He publicado nuevos apuntes de 1º Microbiología y Parasitología: T17.-Bacterias-Gramnegativas-en-los-alimentos.pdf
He publicado nuevos apuntes de 1º Microbiología y Parasitología: T14.-Bacterias-no-relacionadas-con-alimentos.pdf
He publicado nuevos apuntes de 1º Microbiología y Parasitología: T12.-Virus.pdf
He publicado nuevos apuntes de 1º Microbiología y Parasitología: importante-micro.pdf
He publicado nuevos apuntes de 1º Microbiología y Parasitología: PREGUNTAS-MICROBIOLOGIA.pdf
He publicado nuevos examenes de 1º Microbiología y Parasitología: Preguntas-microbiologia-tipo-test.pdf
He publicado nuevos practicas de 1º Microbiología y Parasitología: PRACTICAS-MICROBIOLOGIA-PARTE-1.-CONCEPTOS-TEORICOS.pdf
He publicado nuevos practicas de 1º Microbiología y Parasitología: PARTE-1-EJERCICIOS-DE-PRACTICAS-MICROBIOLOGIA.pdf
He publicado nuevos apuntes de 1º Microbiología y Parasitología: CURVA-PATRON-PRACTICA-2.pdf
apuntes
-
T1- 18 microbiología
He publicado nuevos apuntes de 1º Microbiología y Parasitología: T1- 18 microbiología
He publicado nuevos apuntes de 1º Microbiología y Parasitología: MICROBIOLOGIA.pdf
He publicado nuevos apuntes de 1º Microbiología y Parasitología: TEMARIO-COMPLETO-MICRO-T2-4-18.pdf
ejercicios
-
Actividades y simulacros de micro
He publicado nuevos ejercicios de 1º Microbiología y Parasitología: Actividades y simulacros de micro
He publicado nuevos examenes de 1º Microbiología y Parasitología: Preguntas-EXAMEN.pdf
He publicado nuevos ejercicios de 1º Microbiología y Parasitología: Diferencias-Bacterias-Gram-Positivas-y-Negativas.pdf
He publicado nuevos ejercicios de 1º Microbiología y Parasitología: Diferencias-entre-celulas-procariotas-y-eucariotas.pdf
He publicado nuevos examenes de 1º Microbiología y Parasitología: Cuestionario-t9.pdf
He publicado nuevos examenes de 1º Microbiología y Parasitología: Cuestionario-T1-4.pdf
He publicado nuevos apuntes de 1º Microbiología y Parasitología: TEMARIO-MICRO.pdf
apuntes
-
MICROBIOLOGIA
He publicado nuevos apuntes de 1º Microbiología y Parasitología: MICROBIOLOGIA
He publicado nuevos apuntes de 1º Microbiología y Parasitología: TEMA-3.-taxonomia.pdf
He publicado nuevos apuntes de 1º Microbiología y Parasitología: TEMA-4.-taxonomia.pdf
He publicado nuevos apuntes de 1º Microbiología y Parasitología: T2.-areas-y-aplicaciones.pdf
He publicado nuevos apuntes de 1º Microbiología y Parasitología: T1.-introduccion-2.pdf
He publicado nuevos apuntes de 1º Microbiología y Parasitología: T1-introduccion-02.pdf
He publicado nuevos examenes de 1º Microbiología y Parasitología: Preguntas.pdf
He publicado nuevos apuntes de 1º Microbiología y Parasitología: Diferencias-entre-celulas-procariotas-y-eucariotas-.pdf
He publicado nuevos apuntes de 1º Microbiología y Parasitología: Diferencias-Bacterias-Gram-Positivas-y-Negativas.pdf
apuntes
-
MICROBIOLOGÍA
He publicado nuevos apuntes de 1º Microbiología y Parasitología: MICROBIOLOGÍA
apuntes
-
Resúmenes Temario II
He publicado nuevos apuntes de 1º Microbiología y Parasitología: Resúmenes Temario II